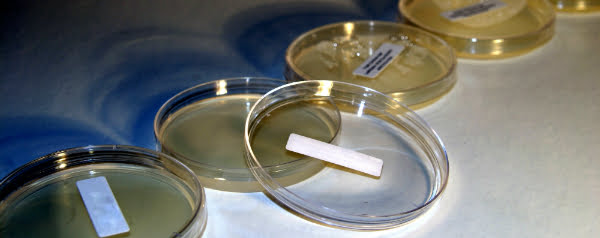

Wetenschappers zijn er voor het eerst in geslaagd een realistisch computermodel te maken van een complete bacterie.
Mycoplasma genitalium is een kleine bacterie met 525 genen. Normaal gesproken is hij te vinden in voortplantingsorganen, waar hij jeuk en een branderig gevoel bij het plassen veroorzaakt. Maar gelukkig is de versie van het Craig Venter-instituut in de VS hier niet toe in staat. Die bestaat namelijk alleen op de computer, en is daarmee het eerste virtuele model van een organisme ooit.
Gesimuleerde bacteriën
Om deze virtuele bacterie te maken, deden Jonathan Karr en collega’s een uitgebreid literatuuronderzoek. Hiermee bepaalden ze 1900 variabelen voor het gedrag van en de werking van processen bij M. genitalium. Aan de hand van genen werden nog 28 hoofdprocessen vastgesteld die in de bacterie plaatsvinden en voor elk werd een apart computerprogramma gemaakt. Deze programma’s, samengevoegd met de variabelen, vormen nu een bacteriemodel op de schaal van genen en moleculen.
Om het model te testen, simuleerden de wetenschappers 128 M. genitalia op een petrischaal en vergeleken ze de resultaten met wat bekend is van de echte versie. Groei, chemische samenstelling en expressie van genen kwamen overeen met de real deal. Complexere simulaties waarbij genen werden uitgeschakeld, waren iets minder precies; die kwamen voor twee derde overeen met de realiteit.
Goedkoop onderzoek
Er is dus nog ruimte voor verbetering; Kerr maakt in het onderzoeksartikel in Cell dan ook duidelijk dat het hier gaat om de eerste versie. Bij het menselijk genoom moest de eerste versie eveneens worden verbeterd, maar nu is het onmisbaar in de wetenschap. En datzelfde zou straks ook voor virtuele organismen kunnen gelden; daarmee zou je heel goedkoop onderzoek kunnen doen naar ziektes. Daarom is de volgende stap om modellen te maken van complexere organismen, met meer genen en processen.
Bronnen: Cell, New Scientist